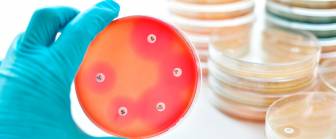

Wie unterscheidet sich die Blutvergiftung von einer falschen Blutvergiftung, der Lymphangitis?
Roter Strich am Arm wird häufig fehlinterpretiert
Viele Menschen schrecken auf, wenn sie einen roten Strich an ihrem Unterarm entdecken. Sofort denkt man bei dem rosa schimmernden Streifen an eine Blutvergiftung. Fälschlicherweise gehen viele Leute davon aus, dass der rote Strich zum Herzen wandert und tödlich endet. Bei der Erscheinung mit dem roten Strich unter der Haut handelt es sich um ein Anzeichen einer Entzündung der Lymphbahnen, der sogenannten Lymphangitis. Zwar kann diese sich zu einer „echten“ Blutvergiftung, einer Sepsis, fortentwickeln, akut lebensbedrohlich ist die Entzündung jedoch nicht.
Entzündung wandert über Gefäße hin zu Lymphknoten
Bei einer Lymphangitis handelt es sich um eine Entzündung der Lymphgefäße, die sich in der Regel gut behandeln lässt. Sie wird wie das schwerwiegende Krankheitsbild der Sepsis ebenfalls landläufig Blutvergiftung genannt. Obwohl die Entzündung der Lymphbahn keine akute Lebensgefahr darstellt, sollte sie ernstgenommen und von einem Arzt behandelt werden. Meist sind Bakterien für die Lymphangitis verantwortlich, seltener auch Pilze oder andere schädliche Krankheitserreger. Folgende Ursachen sind häufig:
- entzündete Verletzungen wie beispielsweise Schürfwunden, Insektenstiche oder Schnittverletzungen
- Entzündung des Gewebes, die mit Eiter einhergeht (Abszesse, Furunkel, Erysipel)
- Entzündung um eine Injektionsnadel
- eine Injektion einer Chemotherapie wurde versehentlich neben der Vene gesetzt
Im Rahmen der Entzündung treten Krankheitserreger wie Bakterien unter die Haut ein und können die Lymphgefäße befallen, sodass sich diese entzünden. Da die Lymphbahnen in Richtung der Lymphknoten verlaufen - also hin zur Körpermitte - verbreitet sich bei vielen Menschen der Gedanke, dass die Entzündung hin zum Herzen führt. Dies ist jedoch in der Art nicht der Fall. Leiden Menschen an Erkrankungen wie Diabetes, Krampfadern oder Fußpilz, so wird die Entstehung einer Lymphangitis begünstigt.
Typisches Anzeichen für die Entzündung ist der rote Strich, der unter der Haut verläuft. Darüber hinaus können betroffene Regionen geschwollen sein und Schmerzen verursachen. Sind die Lymphknoten bereits von der Entzündung betroffen, können diese ebenfalls geschwollen sein oder bei Berührung schmerzen. Zusätzlich leiden die Patienten unter Fieber, einem allgemeinen Krankheitsgefühl und Schüttelfrost.
Körper schonen und Bakterien bekämpfen
Um eine Lymphangitis erfolgreich zu behandeln, verschreiben die meisten Ärzte Antibiotika. Diese bekämpfen die Bakterien, die in den meisten Fällen für die Entzündung verantwortlich sind. Weiterhin lindern alkoholische und kühlende Umschläge die Schmerzen, während entzündungshemmende Salben den Heilungsprozess unterstützen. Nur selten ist eine Operation notwendig, um den jeweiligen Entzündungsherd zu entfernen.
Blutvergiftung (Sepsis) kann tödlich enden
Selbst wenn die Lymphangitis nicht unterschätzt werden sollte, handelt es sich bei einer Sepsis um eine deutlich gefährlichere Krankheit, die als Blutvergiftung bezeichnet wird. Bei der Sepsis verteilt sich eine Infektion über den Blutkreislauf und führt zu schweren Schäden an Organen. Die Sepsis ist eine der häufigeren Todesursachen in Deutschland. Die Rate der Krankheitsfälle, die tödlich ausgehen, liegt bei etwa 25 bis 30 Prozent. Deswegen ist eine schnelle Diagnose und Behandlung unbedingt notwendig.
Wird beispielsweise eine Lymphangitis nicht rechtzeitig behandelt, können Bakterien aus dem Entzündungsherd in die Blutbahnen gelangen und damit eine Sepsis herbeiführen. Zu den weiteren Ursachen gehören:
- entzündeter Insektenstich
- Entzündung einer Zahnwurzel
- Verletzungen wie Schnitte oder Schürfwunden, die sich entzündet haben
- Harnwegserkrankungen
- Lungenentzündungen
Typische Symptome für eine Blutvergiftung gibt es kaum. Die Anzeichen erinnern zunächst an einen grippalen Infekt und werden daher häufig nicht ernst genommen. Da die Sepsis jedoch tödlich enden kann, sollte bei ersten Symptomen ein Arzt oder ein Krankenhaus aufgesucht werden. Folgende Beschwerden können im Rahmen einer Sepsis auftreten:
- Fieber oder Untertemperatur
- beschleunigter Herzschlag
- beschleunigte Atmung
- Verwirrtheit, Desorientiertheit
- Kreislaufprobleme
- Schüttelfrost
Wird die Blutvergiftung nicht umgehend behandelt, vermehren sich die Bakterien weiter, sodass verschiedene Organe von der Entzündung betroffen sind. Bis der genaue Erreger bestimmt ist, vergehen allerdings bis zu 36 Stunden. Man behandelt eine Sepsis zunächst mit einer Mischung aus verschiedenen Antibiotika, die gegen möglichst viele Bakterien wirksam ist. Sobald der Erreger ermittelt ist, kann man mit der gezielten Therapie beginnen.
Dennoch ist die Heilungschance nicht die beste. Im schlimmsten Fall kann sich die Blutvergiftung zur Form einer schweren Sepsis entwickeln oder einen septischen Schock (Kreislaufzusammenbruch) herbeiführen. Häufig müssen Sepsis-Patienten künstlich beatmet oder ernährt werden, weil verschiedene Organe durch die Entzündung beeinträchtigt sind. Kommt es zum Multiorganversagen, funktionieren mindestens zwei lebenswichtige Organe wie Niere, Leber oder Gehirn nicht mehr vollständig. Daher kann sich die Therapie einer Blutvergiftung über einen langen Zeitraum hinweg erstrecken. Dennoch kann sie aufgrund von Komplikationen im schlimmsten Fall zum Tod führen.
aktualisiert am 02.03.2021